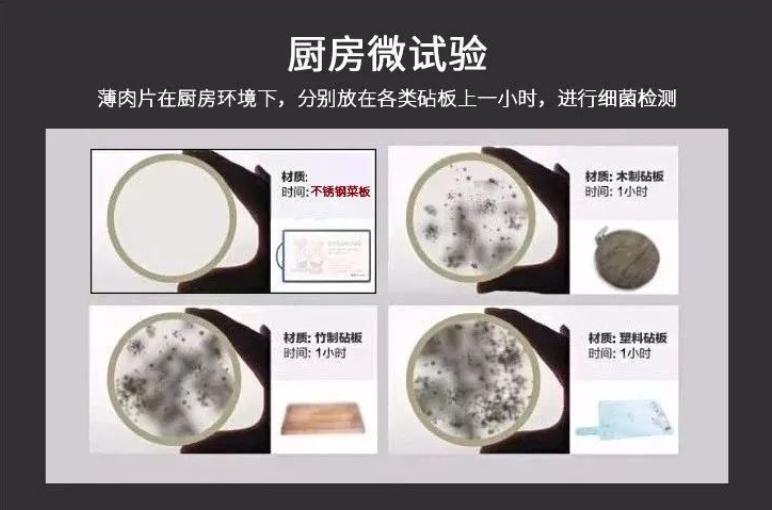
德国什么牌子的不锈钢菜板好,不锈钢的菜板真的很好用吗

大到机床小到各类生活用品,德国品质似乎成了优秀的代名词。这个只有8000万人口的国家却成了紧密与高品质的代表。德国产品已不是某个单一的品牌,而是一个国家品牌,德国产品无疑提升了我们的生活品质,让我们的生活更加的精致。
今天我们不说汽车这样的大家熟悉的德国代表产品,而要说的品牌是的是来自德国的巴本豪森不锈钢菜板。
俗话说,菜板选不对,全家都受罪。菜板是家家户户必备的厨房工具,可见它的重要性。中国人大都用木质菜板。而正是这些菜板,却成了藏污纳垢的关键地方。其实这并不是危言耸听,大家可以看看自己家的菜板一定出现过下图这样的黑斑:


而这些黑斑正是细菌滋养发霉引起的。一旦处理不好,吃进我们的肚子,极易引起肠道感染、拉肚子。更有甚者,一些竹制菜板使用甲醛超标的胶水粘结竹板,严重威胁着我们的健康。

而当我们走进德国家庭,你会发现,大部分德国家庭使用的是不锈钢菜板。正是源于对生活品质的追求,不锈钢菜板才成了他们的第一选择。德国人的厨房,做的不是饭,而是生活品质。

而正是对生活品质的追求,才造就了巴本豪森对技术的完美追求。拥有140年历史的巴本豪森依靠着精湛的技术,打造出了一件又一件的顶级厨具。而这块食品级304不锈钢菜板便是其一。


严苛的选材
巴本豪森所有的产品都采用符合欧盟标准的食品级合金基材,并通过了世界各大权威机构的检测,质量安全令人信服。不锈钢菜板严苛选用食品级304不锈钢板,这种钢材极其耐高温而且具有很强的抗腐蚀性,对碱性溶液机大部分有机酸、无机酸都有很好的耐腐蚀能力。而且可以防霉抗菌、去异味。而一些无良的商家会用使用普通不锈钢,极易造成重金属的迁移,损坏身体健康。

细心的设计
真正的德国产品质量源头在于对细节的把握和精益求精。巴本豪森不锈钢菜板的厚度把持的刚刚好,约为2mm ,厚度仅仅有一元硬币的厚度。因此显得轻便结实不厚重。比起厚重易发霉难存放的普通菜板,它存放轻易不占空间,放在狭小的厨房,能空出多余的空间来放别的厨具。而且具有便携式提手设计,提手光滑圆润呵护双手。


精致的做工

巴本豪森不锈钢菜板表面采用拉丝抛光工艺,防滑、易清洗、不发霉。拉丝工艺主要是使用拉丝的布条往复运动,在菜板上来回摩擦提高表面的光洁度。
抛光工艺则增加了菜板的美观,提高菜板表面耐腐蚀性和耐磨性。经过拉丝抛光后,菜板表面非常的有质感,切菜时就不怕拿不稳刀切刀手了。


不锈钢菜板具有优质的天然金属CU,并均匀分布在菜板结构内,使得菜板不藏污纳垢,具有防霉、防菌的特点。一冲就干净,不像普通菜板还要拿钢丝球刷,用刀刮陷在刀痕的肉渣。

有人做过这样一个试验,将肉片分别放置在不锈钢菜板、木质、竹制、塑料的菜板1小时,通过显微镜观察的细菌含量分别如下:
可见,不锈钢菜板是最少的。有了它,妈妈给宝宝做辅食,每天不重样,宝宝不挑食,吃得开心,妈妈也放心。

防滑不伤刀面,不刺耳
大家都担心是否毁刀,食品级304不锈钢比普通菜刀的硬度更低,所以只要不狠命砍,基本不会伤刀。

经过在不锈钢菜板上切梨进行试验,其发出的声音在50分贝左右,而人说话的声音在40-60分贝,相当于室内谈话,并不会产生不舒服的声音。

而且巴本豪森为了满足大家不同的使用需求,定制了四个不同的尺寸,大家可以尽情的根据自己的需要选择。

德国产品很少去以价格竞争同行业产品,因为所有人都知道,价格并非决定一切,甚至有可能让整个行业都陷入恶性循环,他们更愿意在保证利润的同时,让利润转化成更好的产品和服务完善上。好的厨房用具,其不仅仅提升使用体验,还换来的是更安全卫生的下厨环境。不想每天都吃细菌的话,那这块不锈钢菜板是你上好的选择。
限时优惠:粉丝价仅需58元。
器材库 德国304不锈钢砧板 防霉祛腥 健康易清洗 无刺音不伤刀
¥58
购买